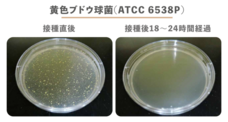
Backer-Founderのプレスリリース画像4

世界初!抗菌防臭、超速乾!天然シナモン由来の匂わないTシャツ『KOUP』がついに日本上陸!
英国発、天然の抗菌・防臭素材であるシナモンからの抽出物を取り入れたTシャツ『KOUP』(クープ)が誕生。クラウドファンディングは開始3日で目標を達成しており、8月20日(木)まで募集を続けます。
繊維業界で10年におよぶ経験を有し、持続可能な繊維の生産や素材を専門とする「KOUP」は7月9日(木)、天然の抗菌・防臭素材であるシナモンからの抽出物を取り入れたTシャツ「KOUP 」の先行販売プロジェクトを開始しました。クラウドファンディングの「CAMPFIRE(キャンプファイヤー)」で目標30万円としたところ、開始から三日間で達成し、注文予約が好調。

▼ 運動や仕事で汗をかきすぎて困る方の救世主とも言えるTシャツ『KOUP』
CAMPFIRE(キャンプファイヤー):https://bit.ly/2W7G0PZ
■抗菌・防臭効果に優れ、長く持続する
汗が臭うのは、バクテリアが汗に含まれるタンパク質を分解して、臭いを伴う酸へ変質させるためです。シナモンTシャツでは臭いを発生するバクテリアが成長できないため、汗をかいたあとのやっかいな臭いが消え、いつでもフレッシュな感じを保てます。 さらに、KOUPはシナモン抽出液をリサイクル品のポリエステルへ浸透させた後、紡績糸、生地、衣服へ加工する特許取得済みの技術を用いています。化学物質や重金属を用いたコーティングは一時的な効果しかなく、5回程度洗っただけで落ちてしまうこともありますが、KOUPの防臭効果はTシャツの寿命期間、持続します。Tシャツを20回洗った後に抗菌特性を試しましたが、効果は全く衰えていませんでした。

■通気性が良く、軽く、水を含んでもすぐ乾く
通常、吸湿性は生地に化学物質をコーティングして得られます。KoupのシナモンTシャツは化学物質に頼らず、素材自身の特性を利用して吸湿性を実現します。毛細管現象を促進する独自の断面形状をもった、より高価なカスタマイズの紡績糸を使用しています。そのため、皮膚から素早く水分が押し出され、運動後も乾いた快適な状態を保ちます。

■身体に優しく、環境にも配慮した
KoupのシナモンTシャツは有害な化学物質を一切使用せず (REACH & OEKO-TEX準拠)、リサイクル素材 (グローバルリサイクル基準で認定された紡績糸メーカー)を採用しています。 ブルーサイン認証を受けた染料ミルを使用して生地を着色しており、衣料工場は世界規模の責任ある認定生産(WRAP)の認証を受けています。当社の製品を真に環境に配慮させるため、持続可能性に関して業界で最も厳しいテストを経たメーカーのみから素材を仕入れています。

■どんな体型のランナーにもフィット
KOUPの画期的なニット方式、Agile-fit™(アジャイルフィット)はどんな体型にも合わせられ、新たに改良された生地はそれまでよりも長く引き伸ばせます。アジャイルフィットを使用することで、生地の引っ張り距離が約30%伸びています。


Tシャツの色はブラック、グレー、ブルー、ピンクの4種類。男性用/女性用、半袖/長袖、XS/S/M/L/XLから選択していただけます。

支援コースは、半袖一枚の4,400円(通常5,500円)から、長袖四枚のセット17,100円(通常25,600円)まで10通りあります。最大8,500円OFFのコースはクラウドファンディング期間限定とします。

■衣服すべてのリサイクルを完全に循環させるビジョンを「KOUP」が掲げた
KOUPは英国発のファッションブランドです。繊維業界で10年におよぶ経験を有し、持続可能な繊維の生産や素材を専門としています。防臭効果のある生地づくりを始めた時、多くの環境問題に気づき、環境にも優しく効果が永続する臭いの解決策を見つけようと決意しました。そこで、KOUP Tシャツが初めて生まれました。KOUP Tシャツはリサイクル素材をなるべく利用して製造されるだけでなく、使い終わったらリサイクルできるようになっています。
ご購入をご希望の方は、以下URLからお申込みをお願いいたします。
CAMPFIRE(キャンプファイヤー):https://bit.ly/2W7G0PZ
ログインするとメディアの方限定で公開されている
お問い合わせ先や情報がご覧いただけます
添付画像・資料
添付画像をまとめてダウンロード
企業情報
| 企業名 | Backer-Founder |
|---|---|
| 代表者名 | 貝殼放大 |
| 業種 | 広告・デザイン |
コラム
Backer-Founderの
関連プレスリリース
-
500年の歴史をもつ「インド刺繍」を守るクラウドファンディングがスタート。伝統的な刺繍工芸ブランド「Tramper」2月24日より先行予約開始
2022年3月2日 12時
-
遊びながら、思考力や想像力・創造力を育てよう!レールブロックの「Qbi Toy」が、マグネット式知育玩具セットをクラウドファンディングで9月上旬より先行発売
2021年9月8日 11時
-
世界最小クラスの最新アダプタ2機種「Alliteシリーズ」が日本上陸!8月24日より期間限定でクラウドファンディングにて先行販売中。1日も経たずに目標達成!
2021年8月26日 11時
-
合計8つのポケットが使えて、高品質デニムの実用性とファッション性を実現した台湾ブランドの「PROFI JEANS」がクラウドファンディングで予約受付中
2021年7月29日 11時
Backer-Founderの
関連プレスリリースをもっと見る